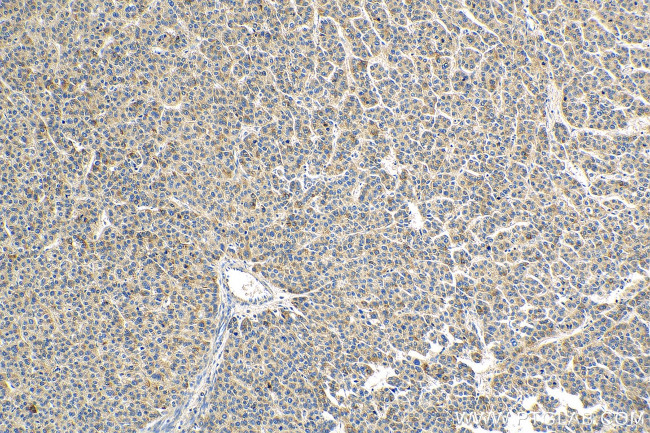
IL15RA Antibody in Immunohistochemistry (Paraffin) (IHC (P))

Search
Proteintech
IL15RA Polyclonal Antibody
{{$productOrderCtrl.translations['antibody.pdp.commerceCard.promotion.promotions']}}
{{$productOrderCtrl.translations['antibody.pdp.commerceCard.promotion.viewpromo']}}
{{$productOrderCtrl.translations['antibody.pdp.commerceCard.promotion.promocode']}}: {{promo.promoCode}} {{promo.promoTitle}} {{promo.promoDescription}}. {{$productOrderCtrl.translations['antibody.pdp.commerceCard.promotion.learnmore']}}
产品信息
16744-1-AP
种属反应
已发表种属
宿主/亚型
分类
类型
抗原
偶联物
形式
浓度
规格
纯化类型
保存液
内含物
保存条件
运输条件
产品详细信息
Immunogen sequence: MSVEHADIW VKSYSLYSRE RYICNSGFKR KAGTSSLTEC VLNKATNVAH WTTPSLKCIR DPALVHQRPA PPSTVTTAGV TPQPESLSPS GKEPAASSPS SNNTAATTAA IVPGSQLMPS KSPSTGTTEI SSHESSHGTP SQTTAKTWEL TASASHQPPG VYPQGHSDTT VAISTSTVLL CGLSAVSLLA CYLKSRQTPP LASVEMEAME ALPVTWGTSS RDEDLENCSH HL (1-231 aa encoded by BC107777)
靶标信息
Interleukin 15 (IL-15RA) is a cytokine receptor that specifically binds IL-15 with high affinity. IL-15 regulates T and natural killer cell activation and proliferation. The IL-15 and IL-2 receptors share two subunits, IL-2R beta and IL-2R gamma, and IL-15RA is structurally related to IL-2RA, an additional IL-2-specific alpha subunit necessary for high affinity IL-2 binding. Unlike IL-2RA, IL-15RA is capable of binding IL-15 with high affinity independent of the other subunits. IL-15RA is thought to enhance cell proliferation and expression of apoptosis inhibitor Bcl-xL and Bcl-2.
仅用于科研。不用于诊断过程。未经明确授权不得转售。
生物信息学
蛋白别名: CD215; cytokine; IL 15 receptor; IL 15 receptor subunit α; IL 15R; IL 15R alpha; IL 15R α; IL-15 receptor subunit alpha; IL15 receptor; IL15 receptor subunit alpha; IL15 receptor subunit α; IL15R; IL15R alpha; IL15R α; IL15RA; Interleukin 15 receptor; Interleukin 15 receptor subunit α; interleukin 15 receptor, alpha; Interleukin-15 receptor subunit alpha; sIL 15R; sIL-15R-alpha; sIL-15RA; sIL15R; similar to interleukin-15 receptor alpha chain precursor; soluble IL 15R; soluble IL15R; unnamed protein product
基因别名: CD215; IL15RA
UniProt ID: (Human) Q13261
Entrez Gene ID: (Human) 3601